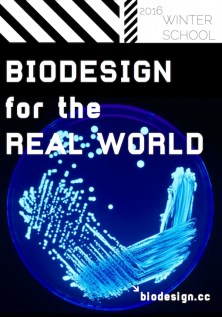

Save the dates! 1-6 February 2016 in Lausanne, CH.
Together with Prof. van der Meer, we will be co-organizing a winterschool with the support of BRAAVOO, a project that aims to develop innovative solutions for real-time in-situ measurement of high impact and difficult to measure marine pollutants.
The wiki stub with the information is just starting to be organized. More information will be added as we go along.